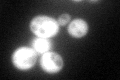
YBR082C
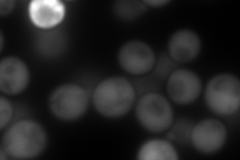
YBR082C
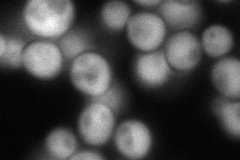
YBR082C
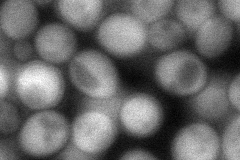
YBR082C
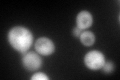
YBR082C
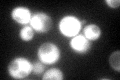
YBR082C
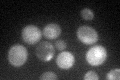
YBR082C

View description
Ubiquitin-conjugating enzyme (E2), mediates degradation of abnormal or excess proteins, including calmodulin and histone H3; interacts with many SCF ubiquitin protein ligases; component of the cellular stress response
Localization:
Intensity:
Fold change:
Significance:
-
C’ GFP library in SD
cytosol133.4 -
N' NOP1pr-GFP in SD

cytosol284.259 -
N' TEF2pr-mCherry in SD
cytosol499.757 -
N' NATIVEpr-GFP in SD
cytosol163.751 -
N' TEF2pr-VC and Cyto-VN in SD
cytosol66.3214 -
C’ GFP library in SD+DTT
cytosol127.670.95No -
C’ GFP library in SD+H2O2
cytosol141.131.05No -
C’ GFP library in Starvation Media
cytosol44.50.33No -
C’ GFP library on the background of Pup2-DaMP

cytosol -
C’ GFP library on the background of CCT mutant

cytosol143.7761.07768No
